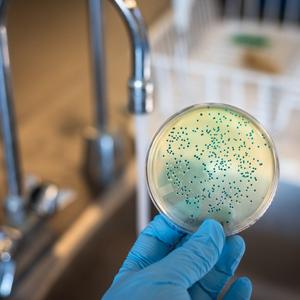

- milvit.cz
- Problémy vody
Problémy vody
Řešíme jakoukoliv úpravu vody pro rodinné domy, bytové domy, firmy, atd. Úprava vody změkčováním, odželezněním či odstraněním manganu, filtrací mechanických nečistot nebo odstraňování dusičnanů a chloridů. Zabýváme se i likvidací bakteriologického znečištění vody a úpravou s tímto související.
Proč nakupit u nás